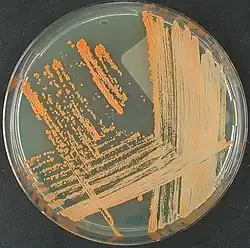

Tsukamurella spumae
| Tsukamurella spumae | |
|---|---|
| Scientific classification | |
| Domain: | Bacteria |
| Kingdom: | Bacillati |
| Phylum: | Actinomycetota |
| Class: | Actinomycetes |
| Order: | Mycobacteriales |
| Family: | Tsukamurellaceae |
| Genus: | Tsukamurella |
| Species: | T. spumae
|
| Binomial name | |
| Tsukamurella spumae Nam et al. 2003[1]
| |
| Type strain | |
| CCUG 48751, CIP 108213, DSM 44113, IFM 10523, JCM 12608, N1171, NCIMB 13947 | |
Tsukamurella spumae is a bacterium from the genus of Tsukamurella which has been isolated from foam from an activated sludge plant in England.[1][2][3]
References
- ^ a b Parte, A.C. "Tsukamurella". LPSN.
- ^ "Details: DSM-44113". www.dsmz.de.
- ^ Nam, Sun-Woo; Chun, Jongsik; Kim, Seungbum; Kim, Wonyong; Zakrzewska-Czerwinska, Jolanta; Goodfellow, Michael (January 2003). "Tsukamurella spumae sp. nov., A Novel Actinomycete Associated with Foaming in Activated Sludge Plants". Systematic and Applied Microbiology. 26 (3): 367–375. doi:10.1078/072320203322497392. PMID 14529179.
External links